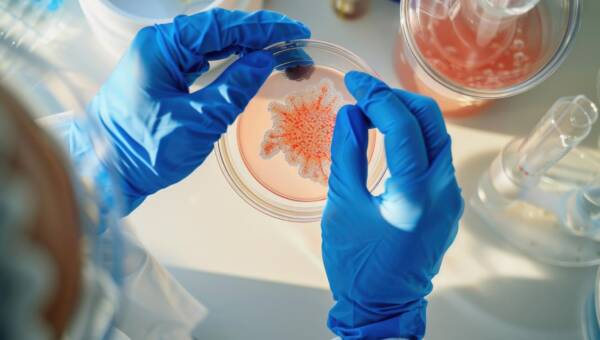
komorki-macierzyste

Porady urodowe ekspertów i czytelniczek

Pielęgnacja skóry na zimowym stoku

Peeling falami radiowymi? Zobacz na czym polega BIO ELECTRO PEELING

Karnawałowe pogotowie kosmetyczne last minute!

Przegląd: metody depilacji. Wybierz najlepszą dla siebie!

Naturalna metamorfoza – naturalne zabiegi medycyny estetycznej!

Ujędrniające zabiegi bankietowe na karnawał

Rodzaje masażu – doskonałe dla duszy i ciała

Co wiesz o wypełniaczach? Poznaj działanie i zastosowanie różnych wypełniaczy

Czego nie wiesz o poprawianiu urody?

Zimowa pielęgnacja dłoni, czyli kosmetyczne patenty na ochronę

Kosmetyki do włosów na zimę

Naturalny wygląd po zabiegu medycyny estetycznej? To jest możliwe!

Nuty zapachowe w perfumach, które są najczęściej wykorzystywane. Czy umiesz je wyróżnić?

Sposoby na piękną skórę w nowym roku
Komórki macierzyste – poznaj ich działanie dla zdrowia i urody!

Jakich składników szukać w kremach dla cery naczynkowej?

Noworoczne postanowienia urodowe

Co przyśpiesza starzenie skóry?

6 kosmetyków które działają jak Photoshop

Skuteczne sposoby walki z trądzikiem młodzieńczym

Pielęgnacyjne zabiegi z herbaty idealne przed Sylwestrem

Zabiegi urodowe przed Sylwestrem – na co się zdecydować, z czym się wstrzymać?

Nowy Rok – zadbaj w nim o swoje piękno!

Kosmetolog radzi: Najbardziej wartościowe składniki, jakie powinny znajdować się w kosmetykach

Osocze bogatopłytkowe. Pięć rzeczy, o których powinnaś wiedzieć

Zabiegi łączone – gra zespołowa w służbie urody

Przegląd kosmetyczny: TOP 5 – Naturalne kremy pod oczy

Kwas i Botoks. Co te zabiegi łączy, a co różni?

Na ratunek spracowanym dłoniom przed Świętami

